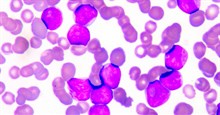
Cách điều trị mới cho bệnh ung thư máu vừa được công nhận

- 5 thói quen vô tình khiến ung thư vòm họng sẽ sớm ghé thăm bạn
- Muốn ăn dưa, cà mà không lo ung thư thì hãy sử dụng chúng đúng cách
- Hóa ra lâu nay chúng ta vẫn đang vô tư sử dụng những chất gây ung thư trong cuộc sống hằng ngày
Nhiều người bị ung thư thường có những cách chăm sóc, kiêng khem thái quá khiến cơ thể không đủ sức đề kháng để có thể chống lại căn bệnh nguy hiểm này.
Theo các chuyên gia của Trung tâm ung thư Parkway, Singapore, cho rằng, chúng ta cần có những hiểu biết đúng đắn về chế độ dinh dưỡng và ăn uống khoa học cho người bệnh ung thư để chiến đấu với căn bệnh. Hầu hết các bệnh nhân bị ung thư thường tìm lên các trang diễn đàn hoặc bạn bè, người thân mách nước về những thực phẩm nên kiêng hoặc nên bổ sung những thực phẩm nào. Những nguồn thông tin này đôi khi mâu thuẫn với nhau và gây nhầm lẫn, khó hiểu hoặc hoàn toàn không có cơ sở khoa học.
Các bác sĩ đúc kết 5 quan điểm sai lầm phổ biến về chế độ dinh dưỡng của bệnh nhân ung thư như sau:
1. Không được ăn đường

Carbohydrate là một trong những nguồn cung cấp năng lượng cần thiết cho cơ thể, đây cũng là nguồn năng lượng để duy trì bộ não chúng ta.
Carbohydrate thường có mặt trong một số loại thực phẩm quen thuộc mà chúng ta sử dụng hằng ngày như trái cây, chế phẩm từ sữa, gạo, các loại mì, bánh quy, thực phẩm từ đậu, rau củ có tinh bột như khoai tây, bắp, bột sắn và hầu hết các loại nước uống, món tráng miệng ngọt.
Vì thế, các chuyên gia về sức khỏe cho rằng, với những bệnh nhân ung thư không nhất thiết phải kiêng đường hoàn toàn. Tuy nhiên cũng không nên tiêu thụ lượng đường quá lớn vì đường không cung cấp giá trị dinh dưỡng mà chỉ có một lượng lớn calo. Khi bạn tiêu thụ lượng đường quá mức quy định sẽ khiến đường trong máu tăng nhanh hơn, tuyến tụy sẽ tạo ra insulin để chuyển hóa đường dẫn đến hội chứng thừa insulin trong máu, hoặc khi cơ thể sản xuất quá mức insulin cũng gây ra phản ứng viêm, làm tăng nguy cơ ung thư.
2. Không sử dụng sửa và những chế phẩm từ sữa

Hormone tăng trưởng tái tổ hợp bò (rbGH) là một loại hormone bò tổng hợp được tiêm vào bò sữa để chúng lớn nhanh và cho nhiều sữa hơn. Hormone này không có hại nhưng nhiều ý kiến lo ngại chúng có thể làm tăng nồng độ các hóa chất trong cơ thể và dẫn đến ung thư.
Đến nay chưa có bằng chứng nào chứng minh về nhận định trên, song nhiều nước như Nhật, Canada, Australia, New Zealand và liên minh châu Âu đã cấm sử dụng hormone rbGH. Trong khi đó, Cục quản lý Dược và Thực phẩm Mỹ vẫn tán thành sử dụng rbGH trong giới hạn không gây hại về mặt sinh học cho cơ thể người. Các chuyên gia ung thư cũng không khuyên bệnh nhân từ bỏ hoàn toàn sữa bò và các chế phẩm từ sữa.
3. Nên ăn mật ong thay đường

Mật ong là một loại thực phẩm rất tốt cho cơ thể. Thành phần dinh dưỡng của mật ong bao gồm chất béo, natri, magie, đồng, sắt, photpho, kali nước và nhiều axit amin, khoáng chất khác. Sử dụng mật ong thay đường sẽ mang lại nhiều lợi ích hơn, hạn chế được bệnh tiểu đường, tim mạch và làm chậm quá trình lão hóa. Mặc dù có nhiều công dụng đối với sức khỏe nhưng không phải đối tượng nào cũng có thể sử dung mật ong, trẻ em dưới 1 tuổi không nên dùng mật ong vì nó có thể gây ra tình trạng mụn nhọt, khó thở ngộ độc, nguy hiểm đến tính mạng. Các bệnh nhân đang hóa trị, xạ trị hoặc trong quá trình cấy ghép tế bào gốc mà sử dụng mật ong sẽ không an toàn. Bởi hầu hết các loại mật ong trên thị trường đều chưa được tiệt trùng, khi sử dụng có thể gây dị ứng hoặc nhiễm trùng cho bệnh nhân. Nếu muốn sử dụng bạn cũng có thể sử dụng mật ong tuyệt trùng, tuy nhiên nhược điểm của những sản phẩm này không giữ được các chất dinh dưỡng trong quá trình tiệt trùng.
4. Không được ăn thịt đỏ

Các loại thịt có màu đỏ là những thực phẩm cung cấp nguồn dưỡng chất dồi dào cho cơ thể như sắt, kẽm và vitamin B12. Những chất dinh dưỡng này rất cần thiết cho cơ thể trong quá trình tạo hồng cầu và haemoglobin. Vậy nên, để đảm bảo cơ thể được cung cấp đầy đủ chất dinh dưỡng bạn có thể sử dụng 1-2 lần một tuần là tốt nhất. Tuy là tốt như vậy, nhưng bạn cũng nên lưu ý không nên sử dụng chúng quá thường xuyên, bởi nó sẽ làm tăng nguy cơ mắc bệnh mạch vành và ung thư.
5. Bệnh nhân ung thư vú kiêng ăn đậu nành

Nhiều người khi bị bệnh thường lo ngại và không sử dụng những sản phẩm chế biến từ đậu nành, họ cho rằng, thực phẩm này không tốt cho bệnh của họ. Điều này hoàn toàn sai lầm. Theo nghiên cứu của các chuyên gia, trong đậu nành có chứa Isoflavones hay còn gọi là phyto-estrogen đây là dưỡng chất thực vật rất tốt, đóng vai trò như estrogen trong cơ thể người. Các chuyên gia còn cho rằng Phyto-estrogen trong đậu nành không gây ra phản ứng tiêu cực đối với các bệnh nhân ung thư vú. Vì vậy, bác sĩ vẫn khuyên bệnh nhân ung thư nên ăn đậu nành và các sản phẩm làm từ đậu nành.
Hy vọng với những thông tin hữu ích trên, bạn sẽ biết cách chăm sóc cho những bệnh nhân ung thư thật tốt, giúp họ có đủ sức khỏe để chiến đấu với bệnh tật.
 AI
AI
 Hướng dẫn AI
Hướng dẫn AI
 ChatGPT
ChatGPT
 Gemini
Gemini
 Thư viện Prompt
Thư viện Prompt
 Công nghệ
Công nghệ
 Học IT
Học IT
 Tiện ích
Tiện ích

Hướng dẫn AI
Hướng dẫn AI
 Ứng dụng
Ứng dụng
 Hệ thống
Hệ thống
 Game - Trò chơi
Game - Trò chơi
 iPhone
iPhone
 Android
Android
 Làng Công nghệ
Làng Công nghệ
 Hàm Excel
Hàm Excel
 Cuộc sống
Cuộc sống
 Khoa học
Khoa học
